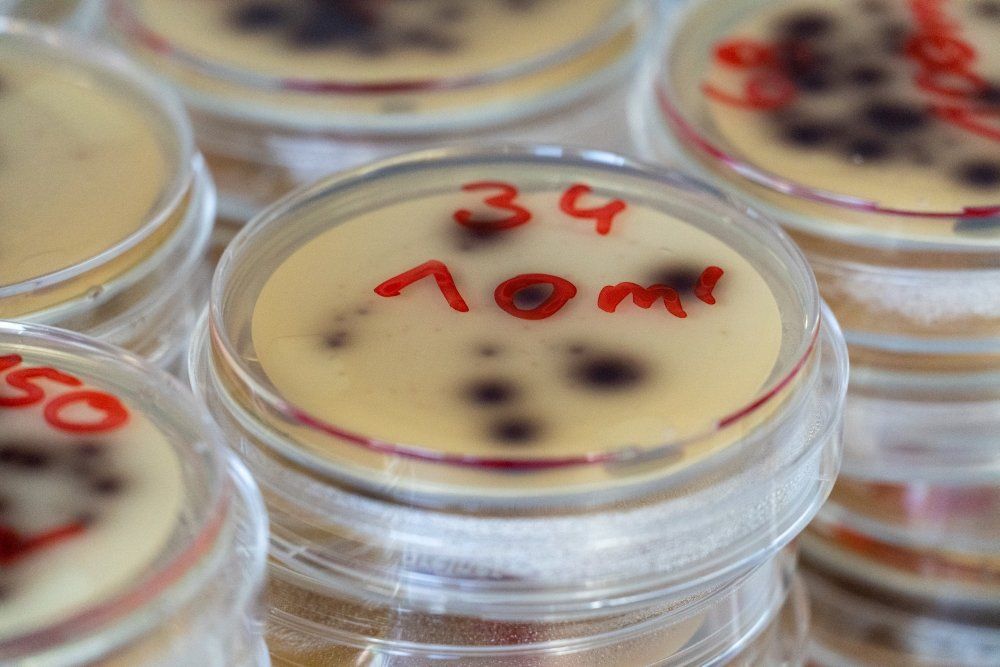

Scientific background
State of the art
Wastewater treatment plants (WWTPs) are designed to reduce the concentration of pollutants and to avoid the direct discharge of wastewater into rivers and oceans. However, conventional wastewater treatment is not sufficient to entirely remove biological contaminants (Hembach et al. 2017; Alexander et al., 2015). Faecal microorganisms, including pathogens, are released by WWTP effluents into rivers and possibly subjected to inactivation while being transported downstream (Agulló-Barceló et al. 2013; Pascual-Benito et al. 2020).
During dry periods, reduction in water flow can lead to higher concentrations of these pollutants as WWTP effluents constitute a greater proportion of the flow in intermittent streams (Muñoz et al. 2009; Pascual-Benito et al. 2020). Extreme rainfall events are also associated with a higher concentration of waterborne pathogens due to the re-mobilization of river sediments (García-Aljaro et al. 2017; Martín-Díaz et al. 2017), the inflow of untreated wastewater from overflow of combined sewer systems and oversaturation and disruption of WWTP performance (Curriero et al. 2001). Increases in microbial pollutant concentrations may result in human health risks due to pathogen exposure (Curriero et al. 2001; Tornevi et al. 2013 and 2014), thereby, compromising water usability (WHO 2017).
This is especially important in the current scenario of climate change. The average annual temperature is gradually increasing and droughts will become more frequent and the frequency of heavy rains will increase at the same time (WHO 2010).
Waterborne pathogen contamination of surface waters and the transmission of infectious diseases via contaminated water are of heighten public health concern (Pandey et al. 2014). The analysis of the microbiological quality of water is an essential step for identifying the sanitary and environmental risks caused by faecal contamination. Assessment of the entire range of pathogen microorganisms is difficult and expensive, so microbial indicators (E. coli and enterococci) are typically used for water quality management (García-Aljaro et al. 2019; WHO 2009). However, research has shown that monitoring faecal indicator bacteria (FIB) may not provide sufficient public health protection given that viruses have different persistence, survival and transport rates in water bodies (Edberg et al., 2000). Thus, water management protocols need to include somatic coliphages (Jofre et al. 2016; McMinn et al. 2017) and/or pathogenic viruses as viral faecal indicators.
Enteric viruses
Enteric viruses reach the aquatic environment through the discharge of WWTP effluents (Lipp et al. 2002; Lee and Kim 2002). Enteric viruses are shed in high numbers in the faeces of infected individuals (105-1012 virus particles per gram of stool) (Farthing 1989; Atmar et al. 2008). While norovirus is known to be involved in many food- and waterborne outbreaks (Amarasiri et al. 2018), also other enteric viruses are widely distributed in the aquatic ecosystem (Varela et al. 2018). Adenoviruses are known to be prevalent throughout the year and for their resistance to disinfection treatments and for their environmental persistence, being suggested as a possible faecal viral indicator (Rames et al. 2016). Hepatitis E virus is of particular interest, giving it is an emerging pathogen in Europe and little information is known about their presence, persistence and survivability in the environment and WWTPs (Fenaux et al. 2019; Wang et al. 2020). On the other hand, Hepatitis A causes around 50% of the total number of hepatitis cases globally and Hepatitis A virus has been linked to several water- and foodborne outbreaks (Bosch et al. 1991, Pinto et al. 2009). Rotavirus is the main aetiological agent of gastrointestinal diseases in children with an estimated number of 215 000 deaths worldwide, particularly important in Less Economically Developed Countries, where vaccination is not obligatory (Crawford et al. 2017).
The detection of enteric viruses using tissue-culture techniques are usually time-consuming and labour-intensive (Hodinka 2013; Jofre and Blanch 2010), although these methods could provide information about infectivity. Additionally, for most enteric viruses, no permissive cell culture systems for isolation on a routine basis are available. An alternative approach is offered by molecular methods based on qPCR detection (USEPA 2012; Karthe et al. 2016; Pei et al. 2012; Ho et al. 2016) and metagenomics (Sanguino et al., 2015). Virus levels in water are typically too low for detection by direct analysis; thus, the detection often involves viral enrichment or concentration. Viruses can be concentrated from environmental samples via different methods such as filtration through electronegative or electropositive filters, ultrafiltration, viral flocculation/precipitation with organic/inorganic flocculants, and ultracentrifugation (Hamza and Bibby 2019; Bofill-Mas and Rusiñol 2020). Similar to concentration methods, a high number of methods and kits are available for nucleic acid extraction with varying efficiency and inhibitors removal capacity. The choice of concentration and extraction method can affect the results and the limit of detection and quantification.
A complete and routine analysis of all potential water-borne pathogens is unsustainable and not viable in cost and practical technological implementation in water management. Since more than a century, bacterial indicators have been defined as those microorganisms associated to the presence of faecal pollution and the potential presence of pathogens in water. However, the analysis of bacterial indicators by culture-based methods has limitations as they display different fate and transport characteristics in aquatic environments when compared to that of viral pathogens. The use of coliphages as indicated for different regulatory agencies and health organizations (US-EPA 2015, WHO 2017) is more appropriate and they have been included in national and international directives and regulations (i.e. recently in the EU regulation for water reuse (Regulation 2020/741, 05.06.2020) and the new EU directive on the quality of water intended for human consumption (COM/2017/0753 final - 2017/0332) already adopted by the European Council (23.10.2020) and pending for final adoption by the European Parliament in coming months. In the new EU drinking water directive (EU DWD, 98/83/EC) a risk-based approach is required and specific implementation plans have to be developed on a national level. The SARA project will provide data to facilitate the risk-based implementation until 2022 as foreseen in the DWD regulations.
SARS-CoV-2
Currently, the SARS-CoV-2 (Severe Acute Respiratory Syndrome) associated COVID-19 pandemic has underlined our lack of knowledge about the survival of coronavirus in surface water and wastewater. SARS-CoV-2 belongs to the Coronaviridae family as does the Severe Acute Respiratory Syndrome coronaviruses (SARS-CoV) and Middle East Respiratory Syndrome (MERS)-CoV, which caused the previous coronavirus outbreaks in 2003 (SARS) and 2009 (MERS), this latter still causing small outbreaks. Since the structure of SARS-CoV-2 is very similar to other human coronaviruses (SARS-CoV, MERS-CoV and 229E CoV, a common cold CoV), they probably share similar physical and biochemical properties and comparable transmission routes. For SARS-CoV and MERS-CoV, there is evidence on both survivals in the environment and effective inactivation measures (WHO 2020). We currently rely on these data to manage risk, but understanding the actual behavior of SARS-CoV-2 in WWTPs and environmental waters is paramount to manage the risks associated with the virus effectively. With the ongoing COVID-19 pandemic, high degree of uncertainty regarding the total number of infections with SARS-CoV-2 across the general population exists. Using SARS-CoV-2 as a biomarker in the context of wastewater-based epidemiology (WBE) might offer an opportunity to estimate the number of unreported or untested cases at a community-level. If the relationship between SARS-CoV-2 occurrence in wastewater and the number of shedding patients is understood, a general biomarker model could be developed to estimate the degree of COVID-19 illnesses in an entire community. An analogous approach demonstrated that the prevalence of Giardia in wastewater is a reliable marker for the infection rate in the community (Nasser et al. 2012). Recent publications showed that the virus shedding in stool of COVID-19 patients in Germany was relatively stable over time and with up to 107 virus copies per g of faeces (Wölfel et al. 2020). So far, only few studies on the presence of SARS-CoV-2 in wastewater exist (Ahmed et al., 2020; Medema et al., 2020; Wu et al., 2020).
A recent report for the concentration and recovery of coronaviruses from water and wastewater samples described the detection of an emerging coronavirus from rats in Riyadh and Barcelona wastewater (Blanco et al 2019). The detection of SARS-CoV-2 in wastewater is based on PCR assays developed for clinical samples. Currently multiple sets of primers and probes for the detection of SARS-CoV-2 are employed targeting different locations of the ORF1b, N and E gene (Charité 2020; National Institute for Viral Disease Control and Prevention China 2020; Institut Pasteur Paris 2020), showing different levels of sensitivity for the analysis of wastewater (Ahmed et al., 2020; Medema et al., 2020). There is only very limited information about the efficiency of concentration and extraction methods for enveloped viruses in wastewater, although some studies have shown that methods like glass-wool, polyethylene glycol (PEG) precipitation or skimmed-milk flocculation are generally capable to concentrate enveloped viruses like SARS in wastewater (Hjelmsø et al. 2017; Blanco et al. 2019). However, more research is required for the development of standardized methods from the concentration to the detection of the SARS-CoV-2 in raw wastewater, particularly from the WBE perspective.
The presence of SARS-CoV-2 in faeces, wastewater and surface water based on the detection of viral genetic material does not necessarily imply viability and infectivity. At the moment, only a few studies have been able to indicate the conditions of viability, infectivity or active replication of SARS-CoV-2 in stools (Wang et al. 2020; Zhang et al. 2020; Xiao et al. 2020). No, or only minimal, active replication in stools was reported by Wölfel et al. (2020) on the basis of observations of viral subgenomic messenger RNAs (sgRNA)-containing cells. So far, in wastewater no infectious SARS-CoV-2 were detected (Rimoldi et al. 2020; Westhaus et al. 2020). The current knowledge is that CoVs viability decreases in wastewater - due to unfavourable temperature, acidic pH, light exposure, high content of particulate solids and pollutants - and this gives confidence that the viral infectivity may be attenuated from faeces to sewage, to WWTPs and then into environment (La Rosa et al. 2020). Additional efforts could be made to assess viral infectivity in wastewater using an engineered cell line with high susceptibility to SARS-CoV-2 and/or to detect infectious viral particles selectively by utilizing viability qPCR, such as ethidium bromide monoazide (EMA), propidium monoazide (PMA), or integrated cell culture (ICC)-RT-PCR/qPCR.

Antibiotic resistance bacteria and Resistance genes
In addition to viruses, wastewater contain a variety of antibiotic resistance bacteria (ARB) and antibiotic resistance genes (ARGs) that can be transmitted into the environment through the discharge of WWTP effluents (Chu et al. 2018; Petrovich et al. 2018; Berendonk et al. 2015). In recent years, the fate of ARBs and ARGs discharged from urban WWTPs and their prevalence in the aquatic ecosystem have received increasing attention (Calero-Cáceres et al. 2017; Jia et al. 2017; Lorenzo et al. 2018; Sabri et al. 2020; Berendonk et al. 2015; Stange et al. 2016 and 2019; Voigt et al. 2020). There is a worldwide consensus that raw municipal wastewater and treated effluents are reservoirs of ARB and ARGs (Ghosh et al. 2009; Zhang et al. 2009) and hotspots for the evolution and spread of antibiotic resistance (Rizzo et al. 2013; Guo et al. 2017). Although treated wastewater contains significantly lower amounts of ARGs than raw wastewater, various researchers have demonstrated that the discharge of treated municipal wastewater increases the quantities of ARGs in the receiving water bodies (Amos et al. 2018; Jäger et al. 2018; Pruden et al. 2012; Nasser et al. 2019). Aquatic environments downstream of WWTPs might be enriched in mobile genetic elements, such as conjugative plasmids, integrative and conjugative elements, transposons and integrons (Di Cesare et al. 2016) that represent effective carriers of ARGs (including multi-resistances).
Next generation sequencing techniques, such as metagenomics, offer the ability to identify all known antibiotic resistance genes within a sample, providing a new approach for the environmental monitoring of antibiotic resistance (Monier et al., 2011; Nesme et al., 2014; Nesme and Simonet 2015). Metagenomic approach entails high throughput shotgun sequencing of environmental DNA (and RNA for metatranscriptomics) (Vogel et al., 2009). The sequences are cleaned, trimmed and both annotated and assembled. The annotation is the comparison of the reads to the appropriate data sets (e.g., Antibiotic genes, plasmid marker genes, viral marker genes, etc.). The assembly involves creating longer sequences (“contigs”) that can be used to reconstruct all or part of the genomes (or viromes) (Delmont et al, 2011; 2012). These longer assembled sequences can be used to identify neighbouring genes and their possible association with plasmid genes, viral genes or integrons.
These techniques have greatly increased the knowledge of the diversity and abundance of ARGs in WWTPs (Bengtsson-Palme et al. 2016; Ju et al. 2019). However, the information about the ARG-carrying species and the genetic contexts remains poorly understood. In the context of ARG dispersion from WWTP effluents, most studies have focused on the analyses of the bacterial resistomes (Ju et al. 2019), while the viral and vesicle fractions have been frequently ignored in spite of being important factors involved in gene transmission in bacteria. Horizontal gene transfer is a major mechanism for spreading of ARGs among different strains or bacterial species (Frost et al. 2005; Nesme and Simonet 2015). In the past, horizontal transfer of ARGs was thought to be largely the result of conjugative plasmids or transposons, with only a minor part being played by other elements such as conjugative elements, pathogenicity islands or bacteriophages (Boerlin and Reid-Smith 2008; Volkova et al. 2014). Recent findings, however, suggest that, particularly in the environment, phages may play a more significant role in the emergence and spread of ARGs than previously expected (Colomer-Lluch et al. 2014; Calero-Cáceres et al. 2014; Calero-Cáceres and Muniesa 2016). Currently, little is known about the mechanisms controlling transport, transfer and accumulation of ARGs in these aquatic systems. Improved monitoring of ARGs in natural water systems can contribute to strategies for combating the proliferation of ARGs through the environment.

Microbial source tracking
Complementary to water quality monitoring using FIB, microbial source tracking (MST) methods provide strategies for the determination of faecal pollution sources in environmental waters. MST methods rely on the association of certain faecal microorganisms with a particular host (human or animal). Various microbiological and genotypic methods have been proposed for MST whereby culture-independent and library independent methods in particular have prevailed (Bernhard and Field 2000; Gómez-Doñate et al. 2016; Ballesté et al. 2020). Environmental samples have been analysed by PCR for either defined bacterial DNA regions (e.g., Bacteroidales or Bifidobacterium spp. sequences) or viral genomes (e.g., CrAssphage) associated to human or animal faeces. Besides of the qualitative determination of the faecal source, quantitative analysis using real-time PCR is also possible and provides information on the contribution of different sources when analysing samples containing a mixture of faecal contents from different origin (Venegas et al. 2015; Gómez-Doñate et al. 2016; Ballesté et al. 2020). MST methods allow a better management of polluted water areas as they can determine the source of faecal pollution, allowing effective restoration measures on the origin. Thus, the strategy for water quality improvement is changing from a Public Health to a One Health approach (Ballesté et al. 2019; Sánchez-Alfonso et al. 2020). Attending to the scope of this project, human host-specific markers are considered related to human pathogens and antibiotic resistances mainly coming through wastewater from cities and hospitals.
Recently, a new DNA bacteriophage was discovered by computational analysis of publicly accessible human faecal metagenomics data and was named crAssphage, which refers to the Cross-Assembly software that was used for its discovery (Dutilhet al, 2014). The single-stranded circular DNA genome is 97 kb in size with 80 predicted open reading frames (ORFs) (Dutilhet al, 2014). Genetically, crAssphage are extremely heterogeneous and can be grouped into at least 10 different genera (Dutilhet al, 2014, Guerin et al., 2018). Various bacteria of the phylum Bacteroidetes have been proposed as the primary hosts of crAssphage as was supported by recent findings that phage ΦCrAss001 from human faeces could be isolated in Bacteroides (Shkoporov et al., 2018). To date, crAssphage has been detected primarily in human stools and rarely in animals (Dutilhet al, 2014, Stachler et al., 2017). In addition, crAssphage can be found at high levels in sewage throughout the year and correlated with the detection of faecal indicators (E. coli, enterococcus, human polyomavirus, and somatic coliphage), suggesting that they could be used for monitoring human faecal pollution of water (Stachler et al., 2017, García-Aljaro et al., 2017, Ahmed et al., 2018).

Bivalve molluscan shellfish
Bivalve molluscan shellfish (BMS), like oysters and mussels, are filter feeders and accumulate bacteria and viruses. Production of BMS in faecal contaminated sea water can lead to the accumulation of pathogenic microorganisms. Enteric viruses such as noroviruses and hepatitis A virus (HAV) has contracted specific interest (Lees 2000) due to a range of outbreaks connected to BMS consumption (EFSA 2011), especially raw oyster consumption (EFSA 2012). In a European baseline survey of noroviruses in oysters, the norovirus prevalence was 34.5 % in investigated production areas (ESFA 2019). In a previous Scandinavian Interreg EU project, mussels were used as sentinels for the analyses of norovirus and E. coli to indicate faecal contamination in sea water (VISK 2013). However, limited knowledge is available with regard to BMS and sediments for integrated monitoring of emerging pathogens, antibiotic resistances, and MST markers.
Current practices for wastewater treatment in low and middle-income countries such as Uganda and Mozambique are insufficient to ensure safe water and basic sanitation (Okalli and Hofstra 2018; Holcomb et al. 2020). The problem of antibiotic resistance is also an issue in Africa. In Uganda, a multi-disciplinary committee was formed to study antibiotic resistance and reported lack of knowledge and problem awareness (UNAS, 2015). At present, there is an urgent need for monitoring the occurrence and distribution of ARB and pathogenic viruses in African aquatic systems.

QMRA
To estimate potential health risks posed by microbiological contaminated water quantitative microbial risk assessment (QMRA) can be used. The modelled risk is based on quantitative measurements of indicators and pathogens, exposure pathways, barriers, specific treatment efficiencies and the risk of infection and illness (Havelaar and Melse 2003; Schijven et al. 2011). QMRA is an inherent part of Water Safety Managements (WHO 2016). However, often QMRA is hampered by a lack of sufficient data. In the proposed project, a broad range of emerging pathogens will be analysed in water resources providing a sound basis for QMRA and key parameter selection for advanced monitoring.



